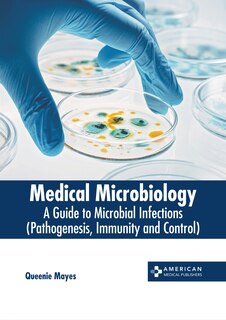
Couverture_Medical Microbiology: A Guide to Microbial Infections (Pathogenesis, Immunity and Control)

Aperçu gratuit du livre Medical Microbiology: A Guide to Microbial Infections (Pathogenesis, Immunity and Control)
213,52 $
Prix en ligne. Les prix et les offres peuvent différer en magasin.
M’expédier cet article
Vérification des stocks…
Acheter maintenant et ramasser en magasin
Vérification des stocks…
Trouver en magasin
Vérification des stocks…
Description
Publié par: American Medical Publishers
Dimensions à l’expédition: 11" H x 8" W x 1" L
ISBN: 9798887402536
Étape de vie: null